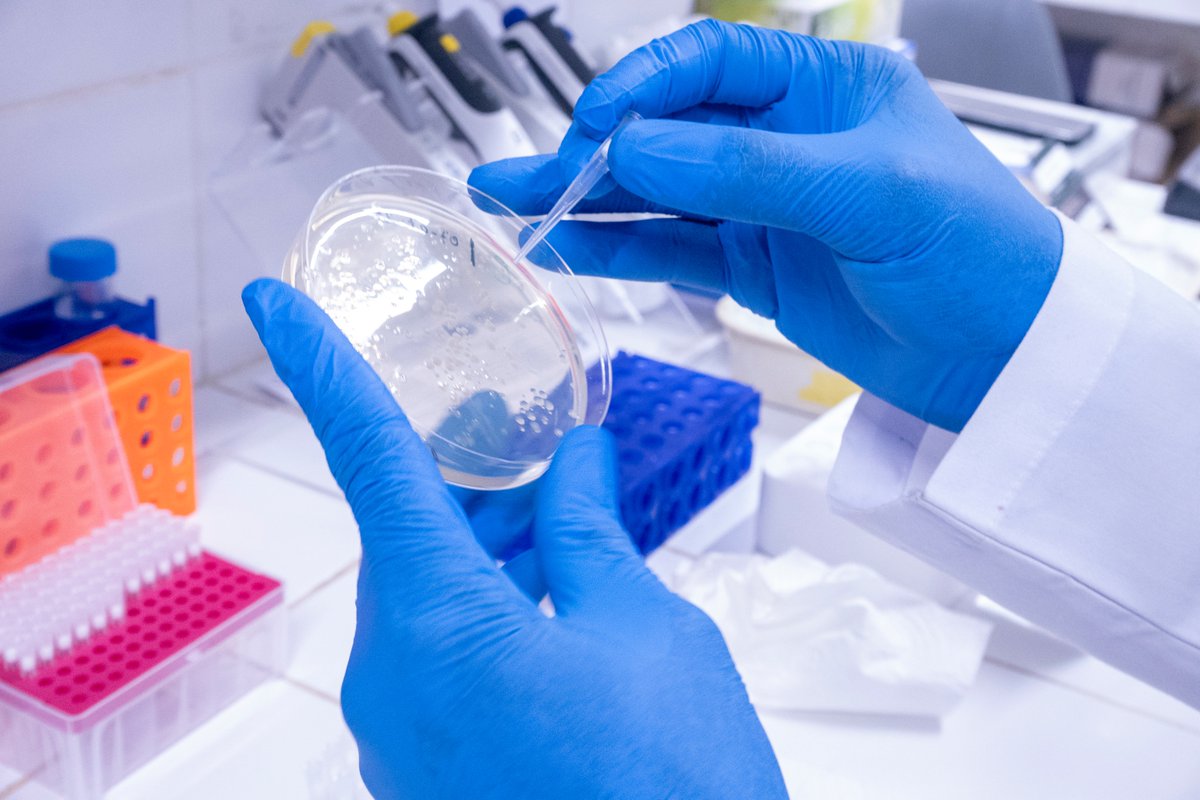
The fight against vector-borne diseases necessarily involves strengthening capacities of researchers in the field of vector-borne diseases.
At ACEME, our researchers are developing plasmid and primer design capabilities.

ACEME AFRICA
@acemeafrica
African Center for Excellence in Molecular Engineering
ID: 1709922116009918464
http://www.acemeafrica.com 05-10-2023 13:23:54
0 Tweet
8 Takipçi
5 Takip Edilen


At ACEME, we are working to put African scientists at the forefront of developing innovative solutions to combat vector-borne diseases on the continent. In partnership with Keele University 🐿️, our researchers are pursuing PhDs in molecular biology focused on mosquitoes.



🌍Biodiversity is in danger. At #IUCNcongress, let’s unite governments, civil society & scientists for real conservation action. Add your voice: bit.ly/4lwyckc Outreach Network for Gene Drive Research





Our report, in partnership with African Leaders Malaria Alliance (ALMA), warns a malaria resurgence could see 750,000 more children lose their lives and cost the next generation $19.7 bn in lost earnings by 2030. Invest in the The Global Fund. economy.zeromalaria.org #MalariaEconomy #ZeroMalaria #StopAtNothing







The World Health Organization (WHO) just released its 2025 #WorldMalariaReport highlighting that progress in the fight against #malaria is under threat as drug resistance rises. Link to the report : who.int/teams/global-m…


The future of the fight against vector-borne diseases in Africa is being written in our universities. At USTTB in Bamako, PhD researcher Madjougou Sissoko is exploring genetic engineering solutions tailored to African realities.Young people must be part of the solution.



“A decisive step in my career.” Lakamy Sylla Sylla, PhD student. In 2024–2025, 5 Malian researchers strengthened skills in genetic modification in Mali. Building African expertise to fight vector-borne diseases, for Africa. #Training #YoungResearchers